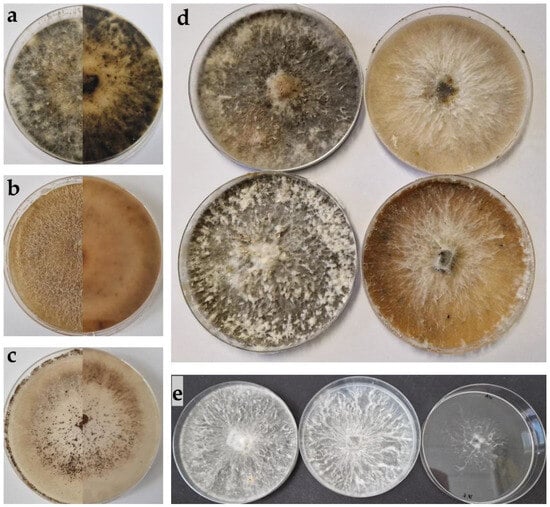

Abstract
A field investigation of olive trees in Istria, Croatia, revealed branch dieback and cracked bark. Samples of diseased branches were collected from eight different locations and analysed. Additionally, meteorological data from two locations were analysed to determine if there was a connection between climatic changes and the appearance of pathogens in the region. Pathogenicity tests were conducted on olive seedlings. This study provides a description of Biscogniauxia and Sordaria species’ morphology and elucidates their phylogeny based on the internal transcribed spacer (ITS), beta-tubulin (TUB2) and translation elongation factor 1-alpha (TEF1- α) regions. This research represents the first documented occurrence of Biscogniauxia mediterranea causing charcoal disease in olive trees in Croatia. Additionally, it is the first report of Biscogniauxia nummularia (Bull.) Kuntze and Sordaria fimicola causing diseases in olive trees anywhere in the world. Furthermore, this study marks one of the initial forays into molecular investigations of these species isolated from olive trees. Considering the potential threat posed by the inherent aggressiveness of Biscogniauxia species, further research is deemed necessary to curb the development of charcoal disease.
1. Introduction
Olive cultivation serves not only as a vital agricultural industry but also as a cherished cultural tradition in numerous regions, playing a pivotal role in the production of olive oil and table olives worldwide. While olive cultivation boasts a rich history, particularly in Mediterranean countries, it has also expanded to other regions with favorable climates such as Australia and California [1], while Italy, Spain and Tunisia rank as some of the world’s foremost producers of olives. While Croatia’s olive production may be relatively modest compared to that of Italy, Spain and Tunisia, it remains a key agricultural sector in numerous coastal regions. According to FAO, the Croatian national production of olives in 2022 was 40,130 tons, while the olive cultivation area covered 19,900 hectares. The production of olive oil in 2021 amounted to 3500 tons [2]. The region’s warm, sunny summers and mild winters create a favourable environment for the cultivation of olive trees. Due to these unique climatic conditions, Mediterranean climate ecosystems host remarkable levels of biodiversity that hold global significance [3]. The Mediterranean littoral vegetation belt encompasses the majority of the Adriatic islands, Central and South Dalmatia and the narrow coastal region of the Croatian littoral. It is divided into three horizontal vegetation zones: the Steno-Mediterranean, Eu-Mediterranean and Sub-Mediterranean. Istria falls within the Eu-Mediterranean region. The absolute minimum temperatures occur here during more months of the year than in the Steno-Mediterranean. In the areas of Rovinj and Poreč, Istria, absolute minimum temperatures begin in October. The rainy period is in the autumn, with the main precipitation minimum occurring in winter, accompanied by a shorter dry period in summer [4]. However, variability in climate can sometimes impact olive production.
Trunk diseases in olive trees target the woody tissues of the tree, encompassing the branches, trunk and occasionally even the roots. These ailments have the potential to result in substantial economic losses within the olive production industry. Trunk diseases affecting olive trees are instigated by a range of fungal pathogens. Among the most prevalent fungal species implicated in these conditions are Cytospora spp., Diplodia spp., Dotihorella spp., Neofusicoccum spp., Phaeoacremonium spp. and Pseudophaeomoniella spp. Cytospora spp. has been identified as an olive pathogen in California [5], Croatia [6], Greece [7], Spain [8] and South Africa [9,10]. Similarly, species from the Botryosphaeriacea family, namely Diplodia spp., Dothiorella spp. and Neofusicoccum spp., have been recognised as pathogens in regions including California [11], Croatia [12,13], Italy [14,15,16], Spain [8,17], South Africa [18] and Uruguay [19]. Phaeoacremonium spp. have been confirmed as a pathogen in Croatia [20], California [11], Italy [15,21] and South Africa [10,18], while Pseudophaeomoniella spp. have been identified as a pathogen in Greece [22], South Africa [18] and Spain [23].
These fungi enter the tree through wounds, naturally occurring openings or pruning incisions [8]. The manifestations of trunk diseases in olive trees can exhibit variability but frequently encompass branch dieback, diminished fruit production and wilting [6,20]. Pycnidia and/or perithecia of certain fungi linked to olive dieback can be discovered embedded in the bark of the affected areas [11]. Additionally, hallmark indications involve the emergence of dark lesions or cankers on the trunk [11,20]. These cankers have the potential to encircle the tree, disrupting the flow of water and nutrients. Trunk diseases can spread among trees through the use of pruning tools, contaminated soil or infected plant material. The dispersal of spores of trunk pathogens can take place through various mechanisms, including rain, wind and both internal or external dissemination facilitated by insects [24,25,26,27].
One of the causative agents of trunk disease in olives is a species from the Biscogniauxia genus [28]. Biscogniauxia is a fungal genus belonging to the family Graphostromataceae, the order Xylariales and the class Sordariomycetes. These fungi are renowned as cosmopolitan and omnipresent wood decomposers, as well as prevalent endophytes [29]. The Biscogniauxia genus (basionym Nummularia Tul. and C. Tul.) was introduced in 1891 for seven species by Kuntze (Table 1), while Nummularia Tul. and C. Tul. was introduced in 1863 by Tulasne and Tulasne.

Table 1.
Biscogniauxia genus—seven species described by Kuntze [30].
B. mediterranea and B. nummularia (Bull.) Kuntze are members of this fungus group. Granata and Sidoti [31] state that B. nummularia is naturally found in beech stands and has not been traditionally regarded as a primary pathogenic agent. Considering that pathogenicity is a variable trait, some species can acquire pathogenicity under certain conditions. According to some authors, B. mediterranea and B. nummularia exist in a latent form within symptomless host tissues during a portion of their life cycle. According to Petrini [32], this would qualify them as endophytes during this latent period. Some studies have demonstrated that these species can rapidly transform from a benign endophyte to a primary pathogen [33,34]. Under stress conditions, they can swiftly infiltrate woody tissues, sometimes becoming noticeable as fungal stroma on branches and trunks [35]. Van Dyk et al. [10] note that drought conditions in the Mediterranean region can influence the aggressiveness of the species and lead to the onset of the disease. The high temperatures and extended periods of summer drought influence the rapid spread of B. mediterranea and B. nummularia [36,37]. B. mediterranea is typically found in association with trees affected by drought, fires and mechanical injuries [38]. Nugent et al. [34] mention water stress as a key factor predisposing trees to susceptibility to attacks by this fungus. Biscogniauxia species are recognised for inducing cankers on the bark of trees. B. mediterranea can affect both the trunk and leaves of olive trees, causing the development of longitudinal bark cracks, detached bark and the withering of the crown [28]. In more severe instances, Biscogniauxia infections can lead to stem girdling, where the cankers encircle the tree trunk, as observed in wild almond [39]. This girdling disrupts the flow of nutrients and water, contributing to branch dieback and, eventually, tree mortality. The pathogen can fatally affect the host within a single growing season [39].
B. mediterranea is among the most common fungal pathogens in the Mediterranean region, leading to charcoal canker (syn. charcoal disease) in different plant species, including oak (Quercus castaneifolia C.A.Mey., Q. brantii Lindl. and Q. suber L.), Prunus scoparia (Spach) C.K.Schneid (syn. Amygdalus scoparia) and Zelkova carpinifolia [38,39,40,41].
On the other hand, B. nummularia is known to cause a disease called strip cankering (syn. beech tarcrust, charcoal canker, hypoxylon canker) on European beech (Fagus sylvatica L.) and sedge (Carex brevicollis DC.) [36,41,42].
Some authors highlight species from the Biscogniauxia genus for its increasing economic impact, which has been attributed to climate change [36,41,43].
The genus Sordaria is classified within the family Sordariaceae, belonging to the fungal order Sordariales and the class Sordariomycetes. These fungi typically inhabit herbivore dung, decaying plant material and, infrequently, coniferous needles. They exhibit a brief life cycle, typically spanning 7 to 12 days [44]. Due to its ease of cultivation in laboratory settings, the fungus is frequently used in microbiology laboratories, for research purposes, as a model organism.
S. fimicola is a homothallic species. Any haploid nucleus within the mycelium can pair with any other nucleus, leading to the abundant production of selfed perithecia alongside hybrid ones. Notably, individual perithecia may give rise to clusters of intermixed hybrid and homozygous asci [45]. An important aspect of this species’ life cycle is that it does not involve the formation of macroconidia. Instead, microconidia are produced, serving as male gametes in sexual reproduction. While microconidia germination is possible, it tends to be very poor [46]. S. fimicola has been recorded as a pathogen on the species Acer palmatum ‘Atropurpureum’ [46]. In a study conducted by Newcombe et al. [47], S. fimicola reduced the growth and fecundity of two out of three populations of Bromus tectorum L., the host from which they had been isolated. The same isolate of S. fimicola reproduced sexually on inoculated host plant tissues as well as in dung after passage through sheep, thus demonstrating a facultative rather than an obligate life cycle.
Currently, 116 Biscogniauxia species and 262 Sordaria species are listed in the MycoBank database. In contrast, the NCBI database includes 37 identified Biscogniauxia species along with 55 unidentified Biscogniauxia isolates, and 20 identified Sordaria species as well as 23 unidentified Sordaria isolates.
The objectives of this research were to identify the causal agent of symptoms observed on olive trees in Croatia; to morphologically characterise and molecularly identify the isolates of phytopathogenic fungal species using PCR and DNA sequence analysis of ITS, TUB2 and TEF1- α gene regions; to assess the isolates’ pathogenicity in pathogenicity tests; and to examine the impact of weather conditions on the appearance of pathogens.
2. Materials and Methods
2.1. Fieldwork and Isolation of Fungi
The symptoms were spotted on olive trees between August and October of 2021 in eight olive orchards in Istria, Croatia while searching for the causative agents of Botriosphaeria dieback of olive trees. The trees exhibited symptoms such as branch and twig dieback, the dieback and shedding of leaves and the premature dropping of fruits. In addition, substantial drying and intensive cracking of the bark on olive trees were observed. After removing the upper layer of the tree bark, dried dark tissue was noticed. The presence of stroma on olive trees was not observed. Samples were gathered from a total of twelve trees, i.e., one in Kaštelir (45°17′30″ N, 13°40′51″ E), one in Fažana (44°56′21″ N, 13°50′18″ E), one in Novigrad (45°20′08.8″ N, 13°33′33.6″ E), three in Španidiga (45°03′02.2″ N, 13°42′43.9″ E), two in Rovinj (45°03′46″ N, 13°42′71″ E), one in Sveti Lovreč (45°09′26″ N, 13°45′02″ E) and three in Poreč (45°13′18.5″ N, 13°36′11.9″ E and 45°13′14.7″ N, 13°36′09.2″ E). Affected trees were aged between 12 and 48 years old. Among these locations, six practised conventional management methods for olive production, while one—located in Vodnjan—followed organic farming practices, and another—situated in Novigrad—employed integrated farming methods. Ten branches from each symptomatic tree were collected and placed in individual sterile black plastic bags. The branches were obtained from areas of the trees exhibiting decline, specifically focusing on sections where the transition from the healthy to the dry part was visible. Each bag was properly labelled and then stored in a portable refrigerator at a temperature of +4 °C. The samples were then promptly transported to the Laboratory for Plant Protection at the Institute of Agriculture and Tourism in Poreč, Croatia, for analysis. The branch samples underwent thorough washing with tap water. Using a sterile surgical scalpel, the bark was carefully removed from the branches, after which the samples were cut using fruit shears. The branch pieces (5 × 5 cm) were immersed in a 10% bleach solution for 30 s, followed by three rinses in sterile distilled water for 30 s. Afterwards, they were arranged on a sterile paper sheet within a laminar flow cabinet to allow for surface drying. Once dried, the pieces were placed onto potato dextrose agar (PDA) supplemented with 25 mg/L of streptomycin. They were then incubated in a dark environment at 25 °C within an incubator. Following the establishment of pure cultures, small pieces of mycelium were transferred using a sterile laboratory needle onto PDA, malt extract agar (MEA) and water agar (WA) for further examination. Pure cultures were preserved in 2 mL cryovial screw cap tubes containing a 50% glycerol solution at temperatures of −20 °C and −80 °C.
2.2. Morphological Characterisation
After incubating for two weeks at 25 °C in the absence of light, pure fungal cultures were examined. From all 10 collected samples per tree (total of 12 trees), the same fungus was consistently isolated. Morphological characterisation was performed on all isolates and, subsequently, one representative isolate per tree was selected for further detailed morphological study. Fungal species from 12 isolates (1 isolate per tree) were characterised by evaluating colony traits (such as colour, shape, elevation, margin, surface and opacity) as well as the features of spores (including colour, shape, presence or absence of septum and dimensions). The morphological characteristics were compared with those from the relevant literature [39,41,44,48].
Macroscopic characteristics were observed using a BOECO zoom stereo microscope BSZ-405 and photographed with a fitted B-CAM16 industrial digital camera and B-View software (Boeckel, Hamburg, Germany). Microscopic characteristics were observed using a BOECO BM-2000 microscope, BOECO BCAM10 camera and B-View software (Boeckel) at the Institute of Agriculture and Tourism Poreč and with an Olympus BX41 microscope (Olympus, Tokyo, Japan) at the Faculty of Agrobiotechnical Sciences Osijek.
2.3. DNA Extraction and Amplification
Fresh fungal mycelia from fungal isolates, that had been cultured on PDA for one week at 25 °C in the dark, were gently scraped from the colony margins using a sterile laboratory needle. This mycelium was then used for the extraction of genomic DNA. The total genomic DNA from the isolates was extracted using a Maxwell® RSC Instrument (Promega, Madison, WI, USA) along with the Maxwell® RSC Plant DNA Kit (Promega). A Maxwell Promega Quantus™ fluorometer (Promega) was used to determine the amount of genomic DNA in samples after DNA isolation. The regions of the internal transcribed spacer (ITS) were amplified using primers ITS4 (5′ TCCTCCGCTTATTGATATGC 3′) and ITS1 (5′ TCCGTAGGTGAACCTGCGG 3′) [49]. Partial beta-tubulin (TUB2) was amplified using oligonucleotide primers Bt2a (5′ GGTAACCAAATCGGTGCTGCTTTC 3′) and Bt2b (5′ ACCCTCAGTGTAGTGACCCTTGGC 3′) [50]. For amplifying portions of the translation elongation factor 1-alpha (TEF1- α), the PCR primer pair of EF-728F (5′ CATCGAGAAGTTCGAGAAGG 3′) and EF-986R (5′ TACTTGAAGGAACCCTTACC 3′) [51] was used. The components of a 25 µL PCR mixture were as follows: 12.5 µL of EmeraldAmp® GT PCR Master Mix (Takara Bio Inc., San Jose, CA), 0.5 µL of each primer (10 µM), 6.5 µL of nuclease-free water and 5 µL of genomic DNA (at a concentration of 5 ng/µL). The PCR was carried out using a MiniAmpPlus Thermal Cycler (Applied Biosystems, Thermo Fisher Scientific, Waltham, MA, USA). The PCR conditions for Biscogniauxia species were as follows: initial denaturation step at 95 °C for 2 min and 30 s, 35 cycles of denaturation at 95 °C for 30 s, annealing at 55 °C for 30 s, elongation at 72 °C for 32 s and final extension at 72 °C for 5 min [52]. The PCR conditions for Sordaria species were as follows: initial denaturation step at 94 °C for 2 min, 40 cycles of denaturation at 94 °C for 30 s, annealing at 55 °C for 45 s, elongation at 72 °C for 1 min and 30 s and final extension at 72 °C for 5 min [53]. Electrophoresis was conducted using a 1% agarose gel at 110 V for 25 min in 1× TAE buffer, using an omniPAC Midi CS-300V electrophoresis power supply (Cleaver Scientific, Rugby, Warwickshire, UK). Following electrophoresis, the PCR products were visualised using an iBright CL1000 Imaging System (Invitrogen, Thermo Fisher Scientific, Waltham, MA, USA).
2.4. DNA Sequence Assembly and Phylogenetic Analysis
Sequencing of the PCR products was carried out by Macrogen Europe (Amsterdam, The Netherlands). The obtained sequences were subsequently edited using Sequencher® 5.4.6. software (Gene Codes, Ann Arbor, MI, USA). These edited sequences were then compared with sequences available in GenBank. For phylogenetic analyses, relevant sequences from the GenBank database were used. The details of these employed sequences are presented in Table 2. The ITS, TUB2 and TEF1- α sequence data were assembled individually using ClustalX2 (UCD Dublin) software. Subsequently, multiple sequence alignments of the ITS, TUB2 and TEF1- α gene regions were combined and adjusted, also using ClustalX2 (UCD Dublin, Dublin, Ireland) software. A phylogenetic tree was made using MEGA11 software (Pennsylvania State University, State College, PA, USA), and the evolutionary history was inferred using the Neighbour Joining method [54].

Table 2.
List of species and isolates used in the phylogenetic analysis and their isolation source, country of origin, GenBank accession number and references.
2.5. Pathogenicity Tests on Olive Seedlings
For a whole plant assay, 3-year-old olive seedlings were inoculated in a greenhouse at the Institute of Agriculture and Tourism in Poreč. In total, two seedlings of the ‘Buža’ variety, two of the ‘Istarska bjelica’ variety, two of the ‘Leccino’ variety, two of the ‘Porečka rosulja’ variety and two of the ‘Rosinjola’ variety were each inoculated with the respective fungal isolate of B. mediterranea, B. nummularia and S. fimicola species. To initiate the inoculation process, wounds measuring 5 mm in diameter were created in the bark (which was wiped with a cotton ball soaked in 70% ethanol) using a sterile cork borer. These wounds were designed to remove the outer bark while preserving the inner bark. A 5 mm diameter mycelium plug from a 2-week-old PDA culture of the fungal isolates was then carefully inserted into each wound. Subsequently, the inoculated wounds were sealed with Vaseline and covered with Parafilm. PDA plugs without mycelium served as a control. The inoculated plants were cultivated in the greenhouse at approximately 23 °C and a relative air humidity of 83% for a duration of 11 months, spanning from January to November 2023, for Biscogniauxia species. To induce more pronounced disease symptoms, the plants underwent water stress and were watered every 10 days throughout the summer months (June to August). For S. fimicola, the inoculated plants were cultivated in the greenhouse at approximately 18 °C and a relative air humidity of 93% for a duration of two months, spanning from October to November 2023, during which they were closely monitored for the presence of symptoms. After the incubation period, observations of changes in the olive trees were recorded and samples were collected in black plastic bags, labelled and analysed. In an attempt to adhere to Koch’s postulate, small fragments of necrotic tissue from the edges of the developed lesions were placed on PDA medium to re-isolate the initially inoculated fungus.
2.6. Analysis of Meteorological Data
Meteorological and hydrological data were retrieved from the database maintained by the Croatian Meteorological and Hydrological Service, sourced from measurement stations close to the study sites. Specifically, information was gathered from two meteorological stations located in the cities of Poreč and Rovinj. Precise details regarding the geographic locations of these measurement stations are accessible through the official website of the Croatian Meteorological and Hydrological Service [76]. Data retrieval for Poreč spanned the years 1982 to 2023, while, in the Rovinj region, data from 1970 to 2023 were collected. The collected dataset comprised key variables, including the average monthly temperature (°C) measured by a dry thermometer, monthly and annual precipitation levels (mm) and average monthly relative air humidity (%). Subsequently, the acquired dataset underwent analysis in Microsoft Office Excel 2021, and linear trends of the observed variables were made.
3. Results
3.1. Field Symptoms
The observed symptoms on the olive trees included branch and twig dieback, canker formations, extensive drying and cracking of the bark, leaf dieback, necrosis and wilting. Upon removing the bark, the wood underneath exhibited a reddish-brown to black-brown discoloration. Additionally, the change in bark colour to reddish occurred as a result of branch decline. Trees infected with Biscogniauxia species displayed all the mentioned symptoms (Figure 1a–d), while those infected with the Sordaria species only showed symptoms of branch and leaf dieback and bark discolouration (Figure 1e).

Figure 1.
Symptoms on olive trees: (a–d) tree bark cracking caused by species of Biscogniauxia; (e) dieback of branches and leaves caused by Sordaria fimicola.
3.2. Morphological Characterisation
The culture isolates were deposited in the collection of the Laboratory for Plant Protection, Department of Agriculture and Nutrition, at the Institute of Agriculture and Tourism in Poreč, Croatia.
3.2.1. Biscogniauxia mediterranea
The colonies expanded to a diameter of 9 cm within 3 days at 25 °C on PDA, and after 4 days on MEA. In contrast, the diameter of the colony on WA reached 7.1 cm after 40 days. The colonies on PDA and MEA exhibited rapid growth, as observed for B. nummularia, with a thick texture and a similar colour. On WA, the colonies appeared whitish to light grey and displayed poor growth (Figure 2). The colony surface colour on PDA differed among isolates, ranging from olivaceous to dark grey with beige spots, or a surface that was lightish grey with white spots, to cinnamon-brown and beige. Typically, it appeared as light grey initially and became darker with age, developing beige spots. The mycelium had a woolly, cottony and fluffy appearance. Reverse colonies were grey to beige with dark spots. The hyphae were aseptate, branched and hyaline. The perithecia exhibited an ovoid-to-tubular shape, measuring 712.3–825.2 µm in length and 111.4–175.7 µm in width (x = 802.2 × 172.9 µm, n = 30). The asci were stipitate and had dimensions ranging from 118.1 to 174.9 µm in length and from 8.7 to 10.8 µm in width (x = 129.2 × 9.2 µm, n = 30). The ascospores were brown and ellipsoidal, measuring 14.7–21.2 µm in length and 6.9–8.8 µm in width (x = 19.9 × 8.2 µm, n = 30).
Figure 2.
(a–c) Upper and reverse view of cultures two weeks after incubation at 25 °C on potato dextrose agar (PDA) medium: (a) Biscogniauxia mediterranea, (b) B. nummularia, (c) Sordaria fimicola. (d) Differences in colony colour between isolates of B. mediterranea on PDA after one month. (e) Difference in the growth of B. mediterranea isolates on PDA (left), malt extract agar (MEA) (middle) and water agar (WA) (right).
3.2.2. Biscogniauxia nummularia
The colonies expanded to a diameter of 9 cm within 5 days at 25 °C on PDA, and after 11 days on MEA. On WA, the colony diameter reached 8.7 cm after 40 days. The colonies on PDA and MEA exhibited rapid growth, with a thick texture and a similar colour. In contrast, the colonies on WA appeared whitish to light beige and displayed poor growth. The colony surface colour on PDA ranged from beige to light orange, occasionally featuring olivaceous spots (Figure 2). The mycelium had a cottony appearance. Reverse colonies were beige with grey discolouration and black to grey spots. The hyphae were septate, branched and hyaline to yellowish. The perithecia exhibited an ovoid-to-tubular shape, measuring 423.1–733.3 µm in length and 289.3–455.3 µm in width (x = 652.5 × 301.2 mm, n = 30). The asci had dimensions ranging from 87.3 to 125.7 µm in length and from 8.1 to 11.1 µm in width (x = 95.2 × 9.1 mm, n = 30). The ascospores were dark brown and ovoid in shape, with tapered ends, measuring 10.2–13.6 µm in width and 6.9–8.7 µm in length (x = 12.9 × 7.8 µm, n = 30).
3.2.3. Sordaria fimicola
The colonies expanded to a diameter of 9 cm within 5 days at 25 °C on PDA, after 6 days on MEA and after 14 days on WA. Colonies developed rapidly on PDA and MEA, while growth on WA was somewhat slower, and the mycelium on the latter was less developed, white and with perithecia. The colony colour on PDA ranged from light in the initial stages of development to dark (Figure 2). The mycelium was aerial, with visible black perithecia formed after 4–5 days on PDA, 9 days on MEA and 19 days on WA. Reverse colonies were dark grey with visible perithecia. The hyphae were septate, branched and hyaline. The perithecium was dark-brown to black, solitary, superficial and pear-shaped, with colourless hairs, measuring 440.2–608.5 µm in length and 227.9–367.9 µm in width (x = 506.3 × 299.4 µm, n = 30). Asci were cylindrical with an apical ring (Figure 3), and contained eight uniseriate ascospores arranged obliquely in rosettes, growing from the base of the perithecium. The asci had dimensions ranging from 125.2 to 167.9 µm in length and from 15.6 to 17.9 µm in width (x = 152.3 × 15.7 µm, n = 30). The ascospores were brown to dark-brown, aseptate, fusiform to ovoid and surrounded by a hyaline, gelatinous sheath, measuring 13.9–18.3 µm in width and 8.1–11.9 µm in length (x = 16.1 × 9.9 µm, n = 30).

Figure 3.
(a,b) Perithecia, asci and ascospores of the species Sordaria fimicola with a visible apical ring. (c,d) Mycelium and hyphae: (c) Biscogniauxia mediterranea, (d) B. nummularia. (e) Differences in spore appearance among species: B. nummularia (left), B. mediterranea (middle), S. fimicola (right).
3.3. Molecular Phylogenetic Identification
The sequences obtained in this study were deposited in the GenBank database and are available under the accession numbers presented in Table 3.

Table 3.
Data on the olive variety from which fungi were isolated, the date of sample collection, location and GenBank accession number.
The BLAST analysis of sequences derived from Biscogniauxia and Sordaria isolates in this study revealed a 99–100% similarity for the ITS, TUB2 and TEF1- α gene regions, aligning closely with corresponding species documented in the GenBank database.
To depict the evolutionary relationships among the isolates, phylogenetic trees were constructed by aligning ITS, TUB2 and TEF1- α sequences, employing the Neighbour Joining method [54]. A comprehensive tree, combining ITS, TUB2 and TEF1- α sequence alignments, was generated, and the optimal trees are depicted in Figure 4, Figure 5, Figure 6 and Figure 7. The percentage values beneath branches represent the replicates in which related taxa clustered together in the bootstrap test, conducted with 1000 replicates [77]. Evolutionary distances, measured in base substitutions per site, were calculated using the Maximum Composite Likelihood method [78]. The Phaeoacremonium iranianum L. Mostert, Grafenhan, W. Gams and Crous isolate R18 BI served as the outgroup in the analysis. Ambiguous positions were excluded through pairwise detection using MEGA11 software [79].

Figure 4.
Phylogenetic tree based on internal transcribed spacer sequence alignment. Sequences identified from olive isolates are highlighted with red rectangles.

Figure 5.
Phylogenetic tree based on beta-tubulin sequence alignment. Sequences identified from olive isolates are highlighted with red rectangles.

Figure 6.
Phylogenetic tree based on translation elongation factor 1-alpha sequence alignment. Sequences identified from olive isolates are highlighted with red rectangles.

Figure 7.
Multilocus tree based on internal transcribed spacer, beta-tubulin and translation elongation factor 1-alpha sequence alignment. Sequences identified from olive isolates are highlighted with red rectangles.
The majority of isolates from the Biscogniauxia genus included in the phylogenetic analysis originated from Quercus spp., while six isolates originated from olive trees. The isolation source of a total of five isolates of Biscogniauxia spp. and seven isolates of Sordaria spp. remains unknown. Notably, isolates of the B. petrensis species were sourced from rock, while an isolate of S. equicola originated from zebra dung. Additional data regarding the isolation source and location of isolates used in the phylogenetic analysis can be found in Table 1. Phylogenetic trees, based on the ITS, TUB2 and TEF1- α genomic regions, and a multilocus phylogenetic tree, collectively affirmed the identification of nine isolates belonging to B. mediterranea, one isolate belonging to B. nummularia and two isolates belonging to S. fimicola. The analysis of the phylogenetic tree revealed that the clustering of isolates was not influenced by host species or geographical location. This observation underscores the robustness of the genetic relationships identified within the studied fungal isolates, indicating that their phylogenetic grouping remains consistent across different host species and locations.
In the specific analyses of individual gene regions, the ITS sequence analysis featured a dataset of 86 nucleotide sequences, culminating in a final dataset of 1536 positions. The TUB2 sequence analysis involved 69 nucleotide sequences, resulting in a final dataset of 1831 positions. Simultaneously, the TEF1- α sequence analysis incorporated 40 nucleotide sequences, with a final dataset of 973 positions. Additionally, the multilocus analysis integrated 38 nucleotide sequences, resulting in a final dataset of 2696 positions. This extensive dataset enabled a comprehensive evaluation of genetic relationships across multiple genomic regions.
The availability of reference material in GenBank for the TUB2 and TEF1- α gene regions, particularly for S. fimicola, was limited. Specifically, only one isolate from the Sordaria genus in GenBank possesses sequences for ITS, TUB2 and TEF1- α gene regions. The isolate is S. equicola, which was previously mentioned as having been isolated from zebra dung. This scarcity of reference material posed a challenge in constructing a multilocus phylogenetic tree, given the necessity for comprehensive data across multiple genomic regions.
3.4. Pathogenicity Test
The first symptoms began to appear approximately between 90 and 100 days after inoculating olive seedlings with Biscogniauxia species. Around the site of inoculation, the colour of the bark started to become reddish. The occurrence of necrosis and branch and twig dieback was also observed (Figure 8). In olive seedlings inoculated with Sordaria species, the first symptoms appeared after only 3 weeks following inoculation. A black mass of perithecia formed at the entry wound, and the plant tissue began to necrotise (Figure 9). Additionally, a change in the colour of the bark was noticed. Similar symptoms were observed in the field. The largest lesion diameter for species B. mediterranea and B. nummularia was observed on the variety ‘Istarska bjelica’, and for S. fimicola on the variety ‘Leccino’. The average lesion lengths for all tested olive varieties were 26.4 mm for B. mediterranea, 15.8 mm for B. nummularia and 10.3 mm for S. fimicola. Regarding olives inoculated with the pure PDA (control plants), no changes were recorded. The fungus re-isolated from the diseased seedlings was identical to the inoculated species, thereby confirming Koch’s postulate.

Figure 8.
Results of pathogenicity tests. (a) Defoliation and branch dieback symptoms on olive seedlings inoculated with Biscogniauxia mediterranea, (b) collected samples from all inoculated olive seedlings, (c) difference between the branch of the control seedling inoculated with potato dextrose agar (PDA) (upper) and the olive branch inoculated with B. nummularia (lower). (d,f) Necrosis on branches caused by Biscogniauxia species: (d,f) branches inoculated with B. mediterranea (left), B. nummularia (middle) and control branches inoculated with PDA (right). (e) Necrosis visible on the cross-section of the branches caused by B. mediterranea (left) and B. nummularia (right). (g) Branch dieback caused by B. mediterranea. (h) Branch dieback and cracking caused by B. nummularia.

Figure 9.
Symptoms of infection on olive seedlings caused by Sordaria fimicola: (a–c) presence of perithecia during inoculation with S. fimicola; (d) differences between infected (left) and control branches (right); (e) change in the colour of the bark to reddish; (f) leaf wilting.
3.5. Meteorological Data
The graphical representations in Figure 10 show the average annual values of temperature, precipitation and relative humidity for the cities of Poreč and Rovinj. The linear trend, represented by the red line, serves as a visual guide, highlighting the discernible patterns of increase or decrease in meteorological variables over the depicted period. Above each graph in the upper right corner, a linear trend equation is displayed, based on which decreases or increases during the observed time period were calculated.

Figure 10.
Graphical representation of meteorological data for the locations Poreč and Rovinj. The average annual values of temperature, precipitation, and relative humidity for each year are marked with blue dots. The red line represents the linear trend, highlighting discernible patterns of increase or decrease in meteorological variables over the depicted period.
Upon closer examination of the data, it becomes evident that both locations, Poreč and Rovinj, have experienced notable shifts in their climatic conditions. Poreč is situated at an elevation of 15 m above sea level, while Rovinj is at an elevation of 20 m above sea level. The average annual temperature during the observed period was 13.9 °C at both locations. Over the observed period, the temperature increased, on average, by 2.3 °C in Poreč and by 2.2 °C in Rovinj.
Regarding the average annual precipitation, the highest amount was recorded in 2010 at both locations (1403 mm in Poreč and 1422 mm in Rovinj), while the lowest was in 1983 (567 mm in Poreč and 510 mm in Rovinj). During the observed period, there was an increase in precipitation of 193.3 mm in Poreč and 59.1 mm in Rovinj.
Conversely, the relative humidity trend reveals a contrasting pattern, with a noticeable decrease at both locations. In Poreč, the relative humidity decreased by 2.6%, while in Rovinj it decreased by 4.3%.
4. Discussion
Patejuk et al. [42] state that many authors have emphasised that B. nummularia behaves mainly as a saprophyte in the northern Mediterranean basin, where the climate is more temperate. In Europe, it is most commonly described as a pathogen of the plant species F. sylvatica [37]. Petrini and Petrini [33] identified the endophytic nature of the fungus, facilitating its rapid transition from a benign endophyte to a primary pathogen, a phenomenon well-acknowledged within the Xylariaceae group of fungi [80]. In a field study conducted in a Portuguese forest in 1974, it was observed that 41.5% of cork oak trees were weakened, and the primary factor contributing to the decline of cork oaks was identified as B. mediterranea [81]. Biscogniauxia species have also been described as pathogens on olive trees in Sfax, Tunisia, which is characterised by a Mediterranean climate [28], but also as an endophyte on olives in Portugal [82]. Another Biscogniauxia species, B. rosaceum, was assessed as having an intermediate level of virulence on olive trees [10]. B. mediterranea has been isolated from olives in Croatia; however, it has not been described as a pathogen on olive trees [83]. The occurrence of B. mediterranea has also been recorded on oak trees (Quercus cerris L., Q. pubescens Willd. and Q. ilex L.) in Croatia, on the island of Cres and in Istria. Considering that oaks make up 82–100% of the trees in these stands [84], a question arises regarding its transmission to olive trees and vice versa. In this study, the species B. mediterranea and B. nummularia were identified as the causative agents of charcoal disease in the olive trees from which samples were taken.
The native habitat of Sordaria species is primarily associated with herbivorous animal dung [85]. Ecologically, these fungi fulfil an important role in the decomposition of organic matter. As mentioned earlier, S. fimicola has been identified as the etiological agent responsible for leaf and twig blight of A. palmatum [46]. On the other hand, while Sordaria species have been isolated from Pinus coulteri D.Don, their pathogenicity towards this plant species has not been established [44]. In this study, the species S. fimicola was identified as the causative agent of olive branch dieback in the olive trees from which samples were taken.
Regarding the phylogenetic analysis, the constrained availability of sequences in GenBank for some loci emphasises the need for continued efforts in genomic research and data deposition to enhance the depth and breadth of genetic information accessible for diverse fungal species. This scarcity of genetic information is particularly noted for S. fimicola, but also for Biscogniauxia species. Despite these challenges, the study proceeded with the available data, acknowledging the limitations and contributing to the understanding of genetic diversity within the constraints of the existing reference material. A genetic analysis of the isolates revealed no significant genetic distinctions compared to the majority of other isolates. As indicated by Patejuk et al. [42] in their research, this implies a potential natural drift of the fungus into Europe.
B. mediterranea exhibits resilience in diverse environmental conditions owing to its notable adaptability. It demonstrates tolerance to a broad spectrum of temperatures and pH levels, exhibits rapid growth and possesses the capacity for expeditiously causing host mortality [38,86]. Saharan and Mehta [87] posit that the observed variability in morphological characteristics among conspecific isolates may be ascribed to a combination of environmental factors, underlying genetic determinants and the influence of mycoviral presence. In a study conducted by Yangui et al. [38], notable correlations were identified between ecological variables, including temperature and rainfall, and certain morphological traits such as the surface colour of the colony and the presence of exudates. Temperature stands out as a key abiotic factor exerting a profound influence on the developmental processes of fungi [88,89]. Henriques et al. [90] found that isolates of B. mediterranea exhibited considerable variability, particularly in culture characteristics such as pigmentation and the presence of aerial mycelium. In this study, a difference in the colour of the colony surface of B. mediterranea was also observed among isolates. The colour ranged from olivaceous-white-grey to brown-beige, and even to a cinnamon hue. The morphological characteristics of all isolates matched previously published data for the mentioned species.
The pronounced genetic variability of B. mediterranea has been associated with its heterothallic mating system, and sexual reproduction contributes to the generation of a substantial number of diverse ascospores [91,92]. Ascospores serve as dispersal and inoculum units capable of being disseminated over extensive distances—facilitated by airborne vectors such as insects—thereby significantly contributing to fungal spread [92,93].
Patejuk et al. [42] emphasise the importance of conducting pathogenicity tests to demonstrate the pathogenic nature of the species. As part of this study, pathogenicity tests were conducted on seedlings of five different olive varieties: ‘Buža’, ‘Istarska bjelica’, ‘Leccino’, ‘Porečka rosulja’ and ‘Rosinjola’. The pathogenicity of isolates on all tested varieties was confirmed. The chosen three-year-old olive seedlings exhibited excellent development. Younger seedlings generally manifest disease or infection symptoms more quickly, facilitating faster results and simpler symptom identification. Moreover, younger seedlings offer improved control over experimental conditions, as they can be equally treated and maintained in controlled environments. This helps eliminate variables and ensures a more reliable assessment of pathogenicity. Those are some of the main reasons why predominantly two-, three-, or four-year-old olive seedlings are used in research studies where pathogenicity tests are conducted.
Henriques et al. [94] note recent observations highlighting an elevated occurrence of B. mediterranea and the manifestation of atypical symptoms on cork, particularly in young trees. These symptoms include cork cracking, the presence of a brown powdery mass in the liber, as well as discoloured and desiccated leaves. These observations raise questions as to whether alterations in the epidemiology of the disease may have occurred, as previously suggested by Sousa et al. [95]. Patejuk et al. [42] assert that the increasing distribution of B. mediterranea and B. nummularia can be ascribed to climate change, specifically the elevation in annual temperatures and the regular incidence of droughts. The reported symptoms in infected olive trees in Tunisia [28] include the development of lengthwise bark cracks, detached bark, the withering of the crown and the extensive chlorosis of the leaves. Intensive bark cracking was also observed in olives from which samples were taken as part of this study. Additionally, as mentioned earlier, a considerable change in climatic conditions was recorded, including an increase in temperature and precipitation, as well as a decrease in relative humidity values at the observed locations. Dminić et al. [84] also underscore the influence of changing climatic conditions in this area and their impact on the emergence of B. mediterranea. High temperatures and low air humidity can cause the faster evaporation of water from the soil and plants. This leads to the dehydration of plants, which can affect their growth, development and survival, consequently impacting their resistance to pathogens and making it easier for pathogens to invade and colonise more rapidly. Changes in temperature and humidity can influence the diversity and balance of ecosystems [96]. Some microorganisms may be sensitive to such changes, leading to disruptions in the ecosystem. Increased temperature can stimulate faster growth and the reproduction of fungi, while decreased air humidity can enhance the dispersal of their spores. Pathogenic fungi may exhibit greater aggressiveness when subjected to stress conditions. Stressful conditions can contribute to the selection and adaptation of pathogenic fungi, leading to changes in the genetic composition of their populations. Consequently, this could potentially result in the emergence of new strains with increased aggressiveness or resistance to specific conditions [97]. Interestingly, the initial detection of B. mediterranea on olive trees in Croatia took place in 2016 in the northern part of Istria during the execution of the VIP project [83]. This project involved the inspection of olive orchards and the collection and analysis of samples from olive trees displaying symptoms of fungal disease. Back then, one isolate of the species B. mediterranea was documented. Presently, the presence of Biscogniauxia spp. has been documented at a total of eight locations in Istria.
Stress caused by elevated temperatures and reduced air humidity is often linked to global climate change. Increased greenhouse gas emissions contribute to climate change, resulting in more extreme weather conditions. According to Kim et al. [98], the Mediterranean region has been recognised as one of the world’s most vulnerable regions to the impacts of climate change.
The spectrum of pathogens identified on distinct hosts shows substantial diversity, potentially linked to the evolutionary history of their hosts or ecological factors, such as the architectural complexity of the host or the extent of the pathogen’s natural range [99]. Co-evolutionary processes between hosts and pathogens, coupled with the ecological criteria of host organisms, contribute to the observed variations in pathogen–host interactions. Host architectural features, including anatomical structures, can influence the susceptibility and resistance to specific pathogens, thereby shaping infection patterns and disease outcomes. Furthermore, the natural range of pathogens, encompassing factors such as geographic distribution and environmental conditions, adds complexity to the myriad host–pathogen relationships evident in diverse ecosystems [100,101,102]. A comprehensive understanding of these factors is essential for unravelling the intricate dynamics of disease ecology and formulating effective strategies for disease management across varied ecological settings.
Patejuk et al. [42] state that findings of B. mediterranea and B. nummularia species are very rare in Europe. They note that, in the last five years, B. mediterranea has been reported in Europe for the first time in history, indicating a growth of Biscogniauxia spp. in central Europe. Furthermore, they emphasise the importance of monitoring these pathogenic species given their aggressive nature and the significant threat they pose. Given all the aforementioned information, it is crucial to monitor the development and movement of this pathogen, particularly in olive production. Pathogens in olive production can pose significant risks, affecting both the quantity and quality of olive yields. They may affect tree health, resulting in a diminished harvest. Pathogens can compromise the quality of olives, affecting attributes such as size, colour and taste. This can impact the marketability and economic value of the olives and their derived products, such as olive oil. Some pathogens can spread easily, posing a risk of transmission to neighbouring olive trees. This can lead to the rapid spread of diseases within an orchard or across different groves. In addition to compromising tree health, the impact of Biscogniauxia infections extends to the quality of timber. The structural integrity of the wood can be compromised, influencing its strength and suitability for various applications. This aspect is particularly relevant for olive producers engaged in the cultivation of trees for furniture and other applications. Moreover, Biscogniauxia infections create potential entry points for secondary pathogens, heightening the susceptibility of trees to additional diseases. This scenario further compounds the overall impact on tree health, emphasising the importance of proactive measures for disease management to mitigate the multifaceted threats posed by Biscogniauxia species.
Given that Sordaria is mostly described in the literature as a saprophytic fungus, control methods against this fungus have not been extensively researched. Effectively managing Biscogniauxia infections presents formidable challenges. Once these fungi establish themselves in affected trees, their persistence becomes a notable concern. Successful management typically requires a multifaceted approach, encompassing cultural practices, strategic pruning and, in certain cases, the necessary removal of severely infected trees. The fungicides carbendazim and propiconazole are reported to be effective in controlling Biscogniauxia sp. [103]. Among the plant-derived antifungal agents, B. mediterranea has demonstrated strong resistance to certain essential oils, including those from Eucalyptus lehmannii Benth. and E. sideroxylon A.Cunn. ex Woolls. However, it exhibited high sensitivity to E. camaldulensis Dehnh oil (IC50 = 3.83 mg/mL) and Malus communis Desf. oil from Zaghouan (IC50 = 1 mg/mL). This sensitivity was observed to be associated with specific compounds present in the essential oils, such as carvacrol, cuminaldehyde, linalool and p-cymene [104]. In terms of biological control, the antagonistic fungus Trichoderma sp. also proved to be effective in controlling Biscogniauxia species [103].
5. Conclusions
This study provides a comprehensive exploration of the morphological characteristics, phylogenetic analysis and symptoms of B. mediterranea, B. nummularia and S. fimicola in olive trees. The findings highlight the versatility and adaptability of Biscogniauxia species in diverse environmental conditions, showcasing their resilience and ability to cause significant damage to olive trees. Pathogenicity tests conducted on various olive varieties confirm the ability of B. mediterranea, B. nummularia and S. fimicola to cause disease, emphasising the importance of proactive measures in disease management. The observed atypical symptoms on cork and olive trees, coupled with changes in climatic conditions, prompt further investigation into alterations in disease epidemiology. It is necessary to monitor the development and movement of these pathogenic species, especially in olive production, where the impact extends beyond tree health to affect olive quantity, quality and economic value. Management strategies, including cultural practices, pruning and the use of fungicides and biological control agents, are essential tools in mitigating the multifaceted threats posed by Biscogniauxia species [103,104]. It is also important to emphasise that the limited availability of sequences in GenBank for specific gene regions underscores the need to continue research in the genomic field and deposit data to enhance the depth and breadth of genetic information accessible for various fungal species.
To our knowledge, this research represents the first documented occurrence of B. mediterranea causing charcoal disease on olive trees in Croatia. Additionally, it is the first report of B. nummularia and S. fimicola causing diseases on olive trees on a global scale. Furthermore, this study marks one of the initial forays into molecular investigations of these species isolated from olive trees.
Author Contributions
Conceptualisation, E.P. and S.G.; methodology, E.P. and S.G.; investigation, E.P., S.G. and K.V., writing—original draft preparation, E.P.; writing—review and editing, S.G., K.V. and J.Ć. All authors have read and agreed to the published version of the manuscript.
Funding
This research was funded by the Croatian Science Foundation Installation Research Project, ‘Natural bioactive compounds as a source of potential antimicrobial agents in the control of bacterial and other fungal pathogens of olives’, Anti-Mikrobi-OL (AMO), UIP-2020-02-7413 and the ‘Young Researchers’ Career Development Project’, DOK-2021-02-2882.
Data Availability Statement
All sequence data are available in NCBI GenBank in accordance with the accession numbers in the manuscript.
Conflicts of Interest
The authors declare no conflicts of interest.
References
- Torres, M.; Pierantozzi, P.; Searles, P.; Rousseaux, M.C.; García-Inza, G.; Miserere, A.; Bodoira, R.; Contreras, C.; Maestri, D. Olive cultivation in the southern hemisphere: Flowering, water requirements and oil quality responses to new crop environments. Front. Plant Sci. 2017, 8, 1830. [Google Scholar] [CrossRef]
- FAO. Food and Agriculture Organization of the United Nations. Crop and Livestock Products. Available online: https://www.fao.org/faostat/en/#data/QCL (accessed on 25 January 2024).
- Cowling, R.M.; Rundel, P.W.; Lamont, B.B.; Arroyo, M.K.; Arianoutsou, M. Plant diversity in mediterranean climate regions. Trends Ecol. Evol. 1996, 11, 362–366. [Google Scholar] [CrossRef]
- Seletković, Z.; Tikvić, I.; Vučetić, M.; Ugarović, D. Climatic features and the vegetation of Mediterranean Croatia. In Šume Hrvatskog Sredozemlja; Akademija Šumarskih Znanosti: Zagreb, Croatia, 2011. [Google Scholar]
- Úrbez-Torres, J.R.; Lawrence, D.P.; Hand, F.P.; Trouillas, F.P. Olive twig and branch dieback in California caused by Cytospora oleicola and the newly described species Cytospora olivarum sp. nov. Plant Dis. 2020, 104, 1908–1917. [Google Scholar] [CrossRef] [PubMed]
- Petrović, E.; Vrandečić, K.; Ivić, D.; Ćosić, J.; Godena, S. First Report of Olive Branch Dieback in Croatia Caused by Cytospora pruinosa Defago. Microorganisms 2023, 11, 1679. [Google Scholar] [CrossRef]
- Rumbos, I.C. Cytospora oleina causing canker and dieback of olive in Greece. Plant Pathol. 1988, 37, 441–444. [Google Scholar] [CrossRef]
- Moral, J.; Agusti-Brisach, C.; Pérez-Rodríguez, M.; Xaviér, C.; Carmen-Raya, M.; Rhouma, A.; Trapero, A. Identification of fungal species associated with branch dieback of olive and resistance of table cultivars to Neofusicoccum mediterraneum and Botryosphaeria Dothidea. Plant Dis. 2017, 101, 306–316. [Google Scholar] [CrossRef] [PubMed]
- Adams, G.C.; Roux, J.; Wingfield, M.J. Cytospora species (Ascomycota, Diaporthales, Valsaceae): Introduced and native pathogens of trees in South Africa. Australas. Plant Pathol. 2006, 35, 521–548. [Google Scholar] [CrossRef]
- van Dyk, M.; Spies, C.F.J.; Mostert, L.; van der Rijst, M.; du Plessis, I.L.; Moyo, P.; van Jaarsveld, W.J.; Haleen, F. Pathogenicity testing of fungal isolates associated with olive trunk diseases in South Africa. Plant Dis. 2021, 105, 4060–4073. [Google Scholar] [CrossRef] [PubMed]
- Úrbez-Torres, J.R.; Peduto, F.; Vossen, P.M.; Krueger, W.H.; Gubler, W.D. Olive twig and branch dieback: Etiology, incidence, and distribution in California. Plant Dis. 2013, 97, 231–244. [Google Scholar] [CrossRef]
- Kaliterna, J.; Miličević, T.; Ivić, D.; Benčić, D.; Mesić, A. First report of Diplodia seriata as causal agent of olive dieback in Croatia. Plant Dis. 2012, 96, 290. [Google Scholar] [CrossRef]
- Ivić, D.; Petrović, E.; Godena, S. Fungi associated with canker diseases on olive in Istria (Croatia). J. Cent. Eur. Agric. 2023, 24, 470–475. [Google Scholar] [CrossRef]
- Lazzizera, C.; Frisullo, S.; Alves, A.; Phillips, A.J.L. Phylogeny and morphology of Diplodia species on olives in southern Italy and description of Diplodia olivarum sp nov. Fungal Divers. 2008, 21, 63–71. [Google Scholar]
- Carlucci, A.; Raimondo, M.l.; Cibelli, F.; Phillips, A.J.I.; Lops, F. Pleurostomophora richardsiae, Neofusicoccum parvum and Phaeoacremonium aleophilum associated with a decline of olives in southern Italy. Phytopathol. Mediterr. 2013, 52, 517–527. [Google Scholar]
- Linaldeddu, B.T.; Rossetto, G.; Maddau, L.; Vatrano, T.; Bregant, C. Diversity and Pathogenicity of Botryosphaeriaceae and Phytophthora Species Associated with Emerging Olive Diseases in Italy. Agriculture 2023, 13, 1575. [Google Scholar] [CrossRef]
- Palou, L.; Taberner, V.; Montesinos-Herrero, C. First Report of Diplodia seriata Causing Loquat Fruit Rot in Spain. Plant Dis. 2013, 97, 421–422. [Google Scholar] [CrossRef] [PubMed]
- Spies, C.F.J.; Mostert, L.; Carlucci, A.; Moyo, P.; van Jaarsveld, W.J.; du Plessis, I.L.; van Dyk, M.; Halleen, F. Dieback and decline pathogens of olive trees in South Africa. Persoonia 2020, 45, 196–220. [Google Scholar] [CrossRef] [PubMed]
- Hernández-Rodríguez, L.; Mondino-Hintz, P.; Alaniz-Ferro, S. Diversity of Botryosphaeriaceae species causing stem canker and fruit rot in olive trees in Uruguay. J. Phytopathol. 2022, 170, 264–277. [Google Scholar] [CrossRef]
- Petrović, E.; Vrandečić, K.; Ćosić, J.; Kanižai Šarić, G.; Godena, S. First Report of Phaeoacremonium iranianum Causing Olive Twig and Branch Dieback. Plants 2022, 11, 3578. [Google Scholar] [CrossRef]
- Raimondo, M.L.; Lops, F.; Carlucci, A. First Report of Phaeoacremonium oleae and P. viticola Associated with Olive Trunk Diseases in Italy. Plant Dis. 2022, 106, 331. [Google Scholar] [CrossRef]
- Markakis, E.A.; Soultatos, S.K.; Koubouris, G.C.; Psarras, G.; Kanetis, L.; Papadaki, A.A.; Goumas, D.E. First Report of Pseudophaeomoniella oleae Causing Wood Streaking and Decay on Olive Trees in Greece. Plant Dis. 2022, 106, 2263. [Google Scholar] [CrossRef] [PubMed]
- Agustí-Brisach, C.; Jiménez-Urbano, J.P.; Raya, M.D.; López-Moral, A.; Trapero, A. Vascular Fungi Associated with Branch Dieback of Olive in Super-High-Density Systems in Southern Spain. Plant Dis. 2021, 105, 797–818. [Google Scholar] [CrossRef]
- Ahimera, N.; Gisler, S.; Morgan, D.P.; Michailides, T.J. Effects of single-drop impactions and natural and simulated rains on the dispersal of Botryosphaeria dothidea conidia. Phytopathology 2004, 94, 1189–1197. [Google Scholar] [CrossRef]
- van Niekerk, J.M.; Calitz, F.J.; Halleen, F.; Fourie, P.H. Temporal spore dispersal patterns of grapevine trunk pathogens in South Africa. Eur. J. Plant Pathol. 2010, 127, 375–390. [Google Scholar] [CrossRef]
- Moyo, P.; Allsopp, E.; Roets, F.; Mostert, L.; Halleen, F. Arthropods Vector Grapevine Trunk Disease Pathogens. Phytopathology 2014, 104, 1063–1069. [Google Scholar] [CrossRef] [PubMed]
- Bertrant, P.F.; English, H. Release and dispersal of conidia of Valsa leucostoma. Phytopathology 1976, 66, 987–991. [Google Scholar] [CrossRef]
- Gharbi, Y.; Ennouri, K.; Bouazizi, E.; Cheffi, M.; Ali Triki, M. First report of charcoal disease caused by Biscogniauxia mediterranea on Olea europaea in Tunisia. J. Plant Pathol. 2020, 102, 961. [Google Scholar] [CrossRef]
- Stadler, M. Importance of secondary metabolites in the Xylariaceae as parameters for assessment of their taxonomy, phylogeny, and functional biodiversity. Curr. Res. Environ. Appl. Mycol. 2011, 1, 75–133. [Google Scholar] [CrossRef]
- Kuntze, O. Revisio Generum Plantarum; Arthur Felix: Leipzig, Germany, 1891; pp. 375–1001. [Google Scholar]
- Granata, G.; Sidoti, A. Biscogniauxia nummularia: Pathogenic agent of a beech decline. For. Pathol. 2004, 34, 363–367. [Google Scholar] [CrossRef]
- Petrini, O. Fungal endophytes of trees leaves. In Microbial Ecology of Leaves; Abdews, J.H., Hirano, S.S., Eds.; Springer: New York, NY, USA, 1991; pp. 179–197. [Google Scholar]
- Petrini, L.; Petrini, O. Xylariaceous fungi as endophytes. Sydowia 1985, 38, 216–234. [Google Scholar]
- Nugent, L.K.; Sihanonth, P.; Thienhirun, S.; Whalley, A.J.S. Biscogniauxia: A genus of latent invaders. Mycologist 2005, 19, 40–43. [Google Scholar] [CrossRef]
- Collado, J.; Platas, G.; Pelaez, F. Identification of an endophytic Nodulisporium sp. from Quercus ilex in central Spain as the anamorph of Biscogniauxia mediterranea by rDNA sequences analysis and effect of different ecological factors on distribution of the fungus. Mycologia 2001, 93, 875–886. [Google Scholar] [CrossRef]
- Luchi, N.; Capretti, P.; Feducci, M.; Vannini, A.; Ceccarelli, B.; Vettraino, A.M. Latent infection of Biscogniauxia nummularia in Fagus sylvatica: A possible bioindicator of beech health conditions. iForest 2015, 9, 49–54. [Google Scholar] [CrossRef]
- Hendry, S.J.; Boddy, L.; Lonsdale, D. Abiotic variables effect differential expression of latent infections in beech (Fagus sylvatica). New Phytol. 2002, 155, 449–460. [Google Scholar] [CrossRef] [PubMed]
- Yangui, I.; Boutiti, M.Z.; Messaoud, C.; Lahbib Ben Jamma, M.; Vannini, A.; Vettraino, A.M. First report of Biscogniauxia mediterranea causing canker on Erica multiflora L. in Tunisia. J. Plant Pathol. 2019, 1001, 1273. [Google Scholar] [CrossRef]
- Rostamian, M.; Kavosi, M.R.; Bazgir, E.; Babanezhad, M. First report of Biscogniauxia mediterranea causing canker on wild almond (Amygdalus scoparia). Australas. Plant Dis. Notes 2016, 11, 30. [Google Scholar] [CrossRef]
- Mirabolpathi, M. Outbreak of charcoral disease on Quercus spp. and Zelkova carpinifolia trees in forest of Zagros and Albroz Mountains in Iran. Iran. J. Plant Pathol. 2013, 49, 257–263. [Google Scholar]
- Zabalgogeazcoa, I.; Pedro, J.; Canalis, R.M. Biscogniauxia nummularia infecting beech (Fagus sylvatica) trees and sympatric plants of the sedge Carex brevicollis. For. Pathol. 2015, 45, 346–348. [Google Scholar] [CrossRef]
- Patejuk, K.; Baturo-Cieśniewska, A.; Pusz, W.; Kaczmarek-Pieńczewska, A. Biscogniauxia Charcoal Canker—A New Potential Threat for Mid-European Forests as an Effect of Climate Change. Forests 2022, 13, 89. [Google Scholar] [CrossRef]
- La Porta, N.; Capretti, P.; Thomsen, I.M.; Kasanen, R.; Hietala, A.M.; Von Weissenberg, K. Forest pathogens with higher damage potential due to climate change in Europe. Can. J. Plant Pathol. 2008, 30, 177–195. [Google Scholar] [CrossRef]
- Ivanová, H.; Onderková, A.; Pristaš, P. Sordaria fimicola-like ascomycete isolated from Pinus coulteri needles in Slovakia. Biologia 2018, 73, 553–559. [Google Scholar] [CrossRef]
- Olive, L.S. Sordaria. In Bacteria, Bacteriophages, and Fungi; King, R.C., Ed.; Springer: Boston, MA, USA, 1974; pp. 553–562. [Google Scholar]
- Ivanová, H. Sordaria fimicola (Ascomycota, Sordariales) on Acer palmatum. Folia Oecologica 2015, 42, 67–71. [Google Scholar]
- Newcombe, G.; Campbell, J.; Griffith, D.; Baynes, M.; Launchbaugh, K.; Pendleton, R. Revisiting the life cycle of dung fungi, including Sordaria fimicola. PLoS ONE 2016, 11, e0147425. [Google Scholar] [CrossRef] [PubMed]
- Hanlin, R.T. Ilustrated Genera of Ascomycetes; APS Press: St. Paul, MN, USA, 1990. [Google Scholar]
- White, T.J.; Bruns, T.D.; Lee, S.B.; Taylor, J.W. 38—Amplification and direct sequencing of fungal ribosomal RNA genes for phylogenetics. In PCR—Protocols and Applications—A Laboratory Manual; Innis, M.A., Gelfand, D.H., Sninsky, J.J., White, T.J., Eds.; Academic Press, Inc.: Cambridge, MA, USA, 1990; pp. 315–322. [Google Scholar]
- Glass, N.L.; Donaldson, G.C. Development of primer sets designed for use with the PCR to amplify conserved genes from filamentous ascomycetes. Appl. Environ. Microbiol. 1995, 61, 1323–1330. [Google Scholar] [CrossRef] [PubMed]
- Carbone, I.; Kohn, L.M. A Method for Designing Primer Sets for Speciation Studies in Filamentous Ascomycetes. Mycologia 1995, 91, 553–556. [Google Scholar] [CrossRef]
- Mazzaglia, A.; Anselmi, N.; Gasbarri, A.; Vannini, A. Development of a Polymerase Chain Reaction (PCR) assay for the specific detection of Biscogniauxia mediterranea living as an endophyte in oak tissues. Mycol. Res. 2001, 105, 952–956. [Google Scholar] [CrossRef]
- Slippers, B.; Crous, P.W.; Denman, S.; Coutinho, T.A.; Wingfield, B.D.; Wingfield, M.J. Combined Multiple Gene Genealogies and Phenotypic Characters Differentiate Several Species Previously Identified as Botryosphaeria dothidea. Mycologia 2004, 96, 83. [Google Scholar] [CrossRef] [PubMed]
- Saitou, N.; Nei, M. The neighbor-joining method: A new method for reconstructing phylogenetic trees. Mol. Biol. Evol. 1987, 4, 406–425. [Google Scholar]
- Rogers, J.D.; Ju, Y.-M.; Candoussau, F. Biscogniauxia anceps comb. nov. and Vivantia guadalupensis gen. et sp. nov. Mycol. Res. 1996, 100, 669–674. [Google Scholar] [CrossRef]
- Hsieh, H.M.; Ju, Y.M.; Rogers, J.D. Molecular phylogeny of Hypoxylon and closely related genera. Mycologia 2005, 97, 844–865. [Google Scholar] [CrossRef]
- Ju, Y.-M.; Rogers, J.D.; San Martín, F.; Granmo, A. The genus Biscogniauxia. Mycotaxon 1998, 66, 1–98. [Google Scholar]
- Mirabolfathy, M.; Ju, Y.-M.; Hsieh, H.-M.; Rogers, J.D. Obolarina persica sp. nov., associated with dying Quercus in Iran. Mycoscience 2013, 54, 315–320. [Google Scholar] [CrossRef]
- Pinto-Sherer, T.J. The Phyloecology of Hypaxylan Sensu Lata; B.A. Florida International University: Miami, FL, USA, 1996. [Google Scholar]
- Sánchez-Ballesteros, J.; González, V.; Salazar, O.; Acero, J.; Portal, M.A.; Julián, M.; Rubio, V.; Bills, G.F.; Polishook, J.D.; Platas, G.; et al. Phylogenetic study of Hypoxylon and related genera based on ribosomal ITS sequences. Mycologia 2000, 92, 964–977. [Google Scholar] [CrossRef]
- Ju, Y.-M.; Rogers, J.D. New and interesting Biscogniauxia taxa, with a key to the world species. Mycol. Res. 2001, 105, 1123–1133. [Google Scholar] [CrossRef]
- Samarakoon, M.C.; Hyde, K.D.; Maharachchikumbura, S.S.N.; Stadler, M.; Jones, E.B.G.; Promputtha, I.; Suwannarach, N.; Camporesi, E.; Bulgakov, T.S.; Liu, J.-K. Taxonomy, phylogeny, molecular dating and ancestral state reconstruction of Xylariomycetidae (Sordariomycetes). Fungal Divers. 2022, 112, 1–88. [Google Scholar]
- Daranagama, D.A.; Camporesi, E.; Tian, Q.; Liu, X.; Chamyuang, S.; Stadler, M.; Hyde, K.D. Anthostomella is polyphyletic comprising several genera in Xylariaceae. Fungal Divers. 2015, 73, 203–238. [Google Scholar] [CrossRef]
- Raimondo, M.L.; Lops, F.; Carlucci, A. Charcoal canker of pear, plum, and quince trees caused by Biscogniauxia rosaceum sp. nov. in southern Italy. Plant Dis. 2016, 100, 1813–1822. [Google Scholar] [CrossRef] [PubMed]
- Henriques, J.; Nóbrega, F.; Sousa, E.; Lima, A. Analysis of the genetic diversity and phylogenetic relationships of Biscogniauxia mediterranea isolates associated with cork oak. Phytoparasitica 2016, 44, 19–34. [Google Scholar] [CrossRef]
- Mirabolfathy, M.; Groenewald, J.Z.; Crous, P.W. The Occurrence of Charcoal Disease Caused by Biscogniauxia mediterranea on Chestnut-Leaved Oak (Quercus castaneifolia) in the Golestan Forests of Iran. Plant Dis. 2011, 95, 876. [Google Scholar] [CrossRef] [PubMed]
- U’Ren, J.M.; Miadlikowska, J.; Zimmerman, N.B.; Lutzoni, F.; Stajich, J.E.; Arnold, A.E. Contributions of North American endophytes to the phylogeny, ecology, and taxonomy of Xylariaceae (Sordariomycetes, Ascomycota). Mol. Phylogenetics Evol. 2016, 98, 210–232. [Google Scholar] [CrossRef] [PubMed]
- Pažoutová, S.; Šrůtka, P.; Holuša, J.; Chudíčková, M.; Kolařík, M. The phylogenetic position of Obolarina dryophila (Xylariales). Mycol. Prog. 2010, 9, 501–507. [Google Scholar] [CrossRef]
- Bien, S.; Damm, U. Prunus trees in Germany—A hideout of unknown fungi? Mycol. Prog. 2020, 19, 667–690. [Google Scholar] [CrossRef]
- Blumenstein, K.; Bußkamp, J.; Langer, G.J.; Langer, E.J.; Terhonen, E. The Diplodia tip blight pathogen Sphaeropsis sapinea is the most common fungus in scots pines’ mycobiome, irrespective of health status-a case study from Germany. J. Fungi 2021, 7, 607. [Google Scholar] [CrossRef]
- Zhang, Z.F.; Liu, F.; Zhou, X.; Liu, X.Z.; Liu, S.J.; Cai, L. Culturable mycobiota from Karst caves in China, with descriptions of 20 new species. Persoonia 2017, 39, 1–31. [Google Scholar] [CrossRef]
- Cai, L.; Jeewon, R.; Hyde, K.D. Phylogenetic investigations of Sordariaceae based on multiple gene sequences and morphology. Mycol. Res. 2006, 110, 137–150. [Google Scholar] [CrossRef]
- Pecchia, S.; Caggiano, B.; Da Lio, D.; Cafà, G.; Le Floch, G.; Baroncelli, R. Molecular Detection of the Seed-Borne Pathogen Colletotrichum lupini Targeting the Hyper-Variable IGS Region of the Ribosomal Cluster. Plants 2019, 8, 222. [Google Scholar] [CrossRef]
- Nygren, K.; Strandberg, R.; Wallberg, A.; Nabholz, B.; Gustafsson, T.; García, D.; Cano, J.; Guarro, J.; Johannesson, H. A comprehensive phylogeny of Neurospora reveals a link between reproductive mode and molecular evolution in fungi. Mol. Phylogenet. Evol. 2011, 59, 649–663. [Google Scholar] [CrossRef]
- Vu, D.; Groenewald, M.; de Vries, M.; Gehrmann, T.; Stielow, B.; Eberhardt, U.; Al-Hatmi, A.; Groenewald, J.Z.; Cardinali, G.; Houbraken, J.; et al. Large-scale generation and analysis of filamentous fungal DNA barcodes boosts coverage for kingdom fungi and reveals thresholds for fungal species and higher taxon delimitation. Stud. Mycol. 2019, 92, 135–154. [Google Scholar] [CrossRef]
- The Croatian Meteorological and Hydrological Service. Available online: https://meteo.hr/infrastruktura.php?section=mreze_postaja¶m=pmm&el=klimatoloske (accessed on 4 December 2023).
- Felsenstein, J. Confidence limits on phylogenies: An approach using the bootstrap. Evolution 1985, 39, 783–791. [Google Scholar] [CrossRef]
- Tamura, K.; Nei, M.; Kumar, S. Prospects for inferring very large phylogenies by using the neighbor-joining method. Proc. Natl. Acad. Sci. USA 2004, 101, 11030–11035. [Google Scholar] [CrossRef]
- Tamura, K.; Stecher, G.; Kumar, S. MEGA 11: Molecular Evolutionary Genetics Analysis Version 11. Mol. Biol. Evol. 2021, 38, 3022–3027. [Google Scholar] [CrossRef]
- Osono, T.; Tateno, O.; Masuya, H. Diversity and ubiquity of xylariaceous endophytes in live and dead leaves of temperate forest trees. Mycoscience 2013, 54, 54–61. [Google Scholar] [CrossRef]
- Macara, A.M. Estimativa em 1975 dos Prejuízos Causados Pelas Principais Doenças do Sobreiro Num Montado da Região Ribatejana; Boletim do Instituto dos Podutos Florestais; Cortiça Nº444: Lisabon, Portugal, 1975. [Google Scholar]
- Materatski, P.; Varanda, C.; Carvalho, T.; Dias, A.B.; Campos, M.D.; Rei, F.; Félix, M.R. Spatial and temporal variation of fungal enophytic richness and diversity associated to the phyllosphere of olive cultivars. Fungal Biol. 2019, 123, 66–76. [Google Scholar] [CrossRef]
- Godena, S.; Ivić, D.; Goreta Ban, S. Uzročnici Djelomičnog ili Potpunog Sušenja Stabala Maslina; Priručnik o Rezultatima VIP Projekta; Institut za Poljoprivredu i Turizam: Poreč, Croatia, 2019; pp. 1–49. [Google Scholar]
- Dminić, D.; Orlović, J.K.; Lukić, I.; Ježić, M.; Ćurković Perica, M.; Pernek, M. First Report of Charcoal Disease of Oak (Biscogniauxia mediterranea) on Quercus spp. in Croatia. Plant Dis. 2019, 103, 2687. [Google Scholar] [CrossRef]
- Fields, W.G. An introduction to the genus Sordaria. Neurospora Newsl. 1970, 16, 14–17. [Google Scholar] [CrossRef]
- Vaninni, A.; Paganini, R.; Anselmi, N. Factors affecting discharge and germination of ascospores of Hypoxylon mediterraneum (De Not.) Mill. Eur. J. For. Pathol. 1996, 26, 12–24. [Google Scholar] [CrossRef]
- Saharan, G.S.; Mehta, N. Sclerotinia Diseases of Crop Plants: Biology, Ecology and Disease Management; Springer: New York, NY, USA, 2008. [Google Scholar]
- Ouedraogo, A.; Fargues, J.; Goettel, M.S.; Lomer, C.J. Effect of temperature on vegetative growth among isolates of Metarhizium anisopliae and M. flavoviride. Mycopathologia 1997, 137, 37–43. [Google Scholar] [CrossRef]
- Gauthier, G.M. Dimorphism in fungal pathogens of mammals, plants, and insects. PLoS Pathog. 2015, 11, e1004608. [Google Scholar] [CrossRef]
- Henriques, J.; Nóbrega, F.; Sousa, E.; Lima, A. Diversity of Biscogniauxia mediterranea within single stromata on cork oak. J. Mycol. 2014, 2014, 324349. [Google Scholar] [CrossRef]
- Vannini, A.; Mazzaglia, A.; Anselmi, N. Use of random amplified polymorphic DNA (RAPD) for detection of genetic variation and proof of the heterothallic mating system in Hypoxylom mediterraneum. Eur. J. Forrest Pathol. 1999, 29, 209–218. [Google Scholar] [CrossRef]
- Jiménez, J.J.; Sánchez, M.E.; Trapero, A. El chancro carbonoso de Quercus III: Dispersión de ascosporas del agente causal. Boletín Sanid. Veg. Plagas 2005, 31, 577–585. [Google Scholar]
- Henriques, J.; Barrento, M.J.; Bonifácio, L.; Gomes, A.A.; Lima, A.; Sousa, E. Factors affecting the dispersion of Biscogniauxia mediterranea in Portuguese cork oak stands. Silva Lusit. 2014, 22, 83–97. [Google Scholar]
- Henriques, J.; Inácio, M.L.; Lima, A.; Sousa, E. New outbreaks of charcoal canker on young cork oak trees in Portugal. Integr. Prot. Oak For. IOBC/Wprs Bull. 2012, 76, 85–88. [Google Scholar]
- Sousa, E.M.R.d.; Santos, M.N.S.; Varela, M.C.; Henriques, J. Perda do Vigor dos Montados de Sobro e Azinho: Análise da Situação e Perspetivas; Instituto Nacional de Investigação Agrária e Veterinária, I.P.: Oeiras, Portugese, 2007. [Google Scholar]
- García, F.; Bestiona, E.; Warfielda, R.; Yvon-Durochera, G. Changes in temperature alter the relationship between biodiversity and ecosystem functioning. Proc. Natl. Acad. Sci. USA 2018, 115, 201805518. [Google Scholar] [CrossRef]
- Brown, A.J.P.; Budge, S.; Kaloriti, D.; Tillmann, A.; Jacobsen, M.D.; Yin, Z.; Ene, I.V.; Bohovych, I.; Sandai, D.; Stavroula, K.; et al. Stress adaptation in a pathogenic fungus. J. Exp. Biol. 2014, 217, 144–155. [Google Scholar] [CrossRef]
- Kim, G.-U.; Chen, D. Climate change over the Mediterranean and current destruction of marine ecosystem. Sci. Rep. 2019, 9, 18813. [Google Scholar] [CrossRef]
- Burdon, J.J.; Silk, J. Sources and Patterns of Diversity in Plant-Pathogenic Fungi. Phytopathology 1997, 87, 664–669. [Google Scholar] [CrossRef]
- Ostfeld, R.S.; Keesing, F.; Eviner, V.T. The Ecology of Infectious Diseases: Progress, Challenges, and Frontiers. In Infectious Disease Ecology: Effects of Ecosystems on Disease and of Disease on Ecosystems; Ostfeld, R.S., Keesing, F., Eviner, V.T., Eds.; Princeton University Press: Princeton, NJ, USA, 2008; pp. 469–482. [Google Scholar]
- Rupp, S.; Sohn, K. Host-Pathogen Interactions: Methods and protocols. In Methods in Molecular Biology; Walker, J.M., Ed.; Humana Press: Totowa, NJ, USA, 2009; Volume 470. [Google Scholar]
- Lugtenberg, B. Principles of Plant-Microbe Interactions: Microbe for Sustainable Agriculture; Springer: New York, NY, USA, 2015. [Google Scholar]
- Karami, J.; Kavosi, M.R.; Babanezhad, M.; Kiapasha, K. Integrated management of the charcoal disease by silviculture, chemical and biological methods in forest parks. J. Sustain. For. 2018, 37, 429–444. [Google Scholar] [CrossRef]
- Yangui, I.; Boutiti, M.Z.; Boussaid, M.; Messaoud, C. Essential Oils of Myrtaceae Species Growing Wild in Tunisia: Chemical Variability and Antifungal Activity Against Biscogniauxia mediterranea, the Causative Agent of Charcoal Canker. Chem. Biodivers. 2017, 14, e1700058. [Google Scholar] [CrossRef]
Disclaimer/Publisher’s Note: The statements, opinions and data contained in all publications are solely those of the individual author(s) and contributor(s) and not of MDPI and/or the editor(s). MDPI and/or the editor(s) disclaim responsibility for any injury to people or property resulting from any ideas, methods, instructions or products referred to in the content. |
© 2024 by the authors. Licensee MDPI, Basel, Switzerland. This article is an open access article distributed under the terms and conditions of the Creative Commons Attribution (CC BY) license (https://creativecommons.org/licenses/by/4.0/).










